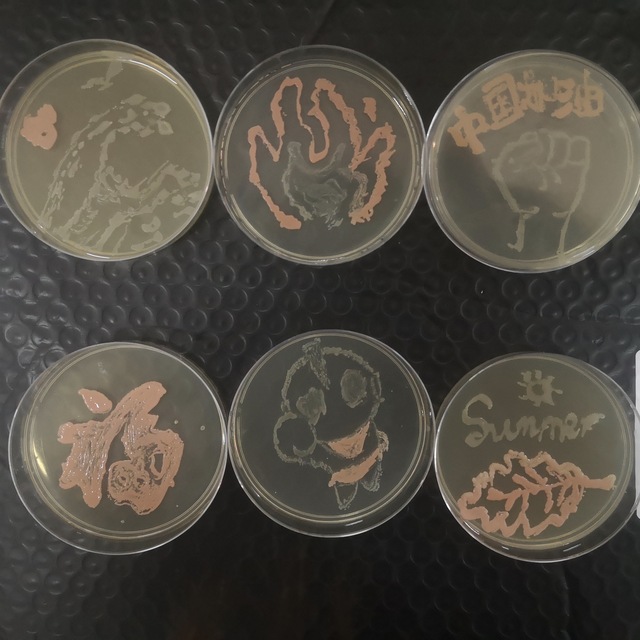

本网讯 2021年5月12日6点,校第二届妙皿生花决赛在生物与食品工程学院综合实验室拉开序幕。本次大赛由校团联合主办,生物药物与健康协会承办,共计三百余名同学参加了比赛。生物制药教师党支部教师钱森和、刘艳、孔芳、唐红进和李闯在赛前谋划、比赛材料的准备、比赛过程的指导、作品的评选等过程给与了大量的指导与支持。

本次比赛分为初赛和决赛,在经历线上初赛后,有50位参赛选手脱颖而出,顺利进入决赛。决赛之前,邀请了生物制药专业王洲老师为决赛选手培训了无菌操作技术和培养皿作画技巧。参赛同学发挥了自己的奇思妙想,用菌种在培养皿上勾勒出美丽的画卷。《白孔雀》作品展现出了不畏困难,敢于标新的自信美;《学习雷锋》作品弘扬了中华民族传统美德,宣扬正能量;《浪》作品寓意着在2021年乘风破浪,疫情稳定,迎接美好新生活。本次比赛评选出一等奖两名,二等奖四名,三等奖六名。此次比赛不仅丰富了校园生活,营造了浓厚的校园文化氛围,让同学们切身理解生物知识,用实践感受科学。

自开展党史学习教育以来,生物制药教师党支部切实贯彻落实学校党委的要求,把“学党史、悟思想,我为师生办实事”实践活动作为党史学习教育的重要内容,带领专业教师扎实做好新时代的人才培养,稳步推动学生考研、就业和本科生导师制等工作;在强化师风师德建设的同时,坚守为党育人、为国育才。
(文:梁文雅、钱森和;图:李佳雪;审核:王辉;编辑:郑文君)





